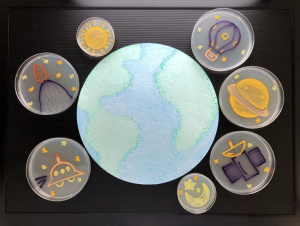

İlgi çekmek için var olan konseptlere yeni isimler koyup, yenilikmiş gibi davranılmasına az çok alıştık, evet. Ama Biyo Sanat, her sanat dalı gibi tartışılabilir sınırlara sahip olsa da, 20. yüzyıl sonlarında ortaya çıkmış bir sanat biçimi. Bilim ve sanatın bir araya geldiği, yaşayan bir canlının / canlıların kullanıldığı, bu canlıların gelişim sürecinin de sanatın bir parçası olarak değerlendirildiği tüm eserlere biyo sanat diyebiliriz.
Bu alanda birçok etik tartışmalar tabii ki var. Canlıların, hayat kalitelerini hatta hayatlarını riske sokulduğu bir takım saçmalıklar yapıp buna sanat diyenler çıkacaktır. Bu yazıda bu konulara ve etik tartışmalara özellikle girmemeyi tercih ediyorum. Bunun yerine mikroorganizmalarla yapılan ‘canlı sanat’ eserleri nasıl ortaya çıkıyor, hatta bunları yaşam alanlarımıza karşılıklı çıkar sağlayacağımız şekilde, nasıl dahil ederiz bunlara bakalım.
Bakterilerle Sanat

Bakterilerle sanat, ya da agar sanatı biyo sanatın en popüler dallarından biri. American Society for Microbiology (ASM) her sene bu alanda yarışma bile düzenliyor. Petri, tuval ve mikroorganizmalar da boya oluyor.
Agar Nedir?
Agar, deniz yosunu türlerinden elde edilen doğal bir jel maddesidir. Kendisi canlı değildir, ama mikroorganizmaları ve mantarları büyütmek için bir araç gibidir. Bazı yemek yapımlarında da kullanılabilir ama o bambaşka bir konu tabii.
Biliminsanları (özellikle agar sanatında) agar kullandıklarında, kullandıkları alanı “besiyeri” veya “besi ortamı” diye adlandırıyorlar. Agar, ilk başta sıvıdır, ama soğuduğunda katılaşır. Agar alanlarının üzerine de renklendirilen mikroorganizmalar eklenir ve birkaç gün büyümeleri ve sanatın ortaya çıkmaları için beklenir.
ASM 2019 yarışmasından bazı örneklerle Agar Sanatıyla tanışın:

Yaşayan Heykeller
Biyo sanatın bir başka dalı da heykeller. Bu heykellerin bazılarıiçin mantarlar kullanılıyor ama bir çoğu mikrobiyolojik yaşama elverişli yüzeylerin üzerinde canlıların büyümesi ile oluşturuluyor.
Bu alandaki ünlü projelerden biri de Ecologic Studio‘nun mikrobik yaşama açık, dijital biyo heykeli. Bir projelerinde, “Yaşam” kavramını, dijital destekli yeni bir biçime çeviriyorlar.
Bu proje, canlı organizmalarla “işbirliği” içinde geliştirilmiş. Dünya üzerindeki en eski organizmalar arasında yer alan siyanobakterilerin eşsiz biyolojik zekası, bu projede yeni bir biyo-dijital heykel biçiminin parçası olarak bir araya getirilmiş.
Heykelde kullanılan fotosentetik siyanobakteriler, sistemin biyolojik zeka birimlerini oluşturan bireysel üçgen hücrelere veya biyo-piksellere (heykel üzerindeki küçük odacıklara) bir biyojel ortamında aşılanıyor. Fotosentezle çalışan metabolizmaları, güneş enerjisini oksijene ve biyokütleye dönüştürüyor, yani kısaca büyüyorlar.
Biyo Sanat Dalları
Tabii biyo sanat, sadece bakterilerle sanat ya da yaşayan heykeller değil. Biyoloji, genetik mühendislik, biyoteknoloji ve yaşam bilimleri gibi tüm alanlarla sanatın kesişimini temsil ediyor. Tüm canlı organizmalar veya biyolojik materyallerle kullanılan eserlere biyo sanat diyebiliriz.
Bugün, henüz emekleme aşamasında olan bu sanat dalının, geleceği şekillendirebilecek potansiyelini keşfetmek için heyecanla takip ediyoruz. Yapay zeka ve mikrobiyolojinin buluştuğu bu alanda, canlı organizmalardan oluşturulan araçlarla hayatımızın nasıl kolaylaşacağını düşünmek bile ilham verici. Biyo mimari eserlerini incelediğinizde, bu sanat dalının gelecekte bizi nelerin beklediğini daha iyi anlayabilirsiniz. Bu alandaki gelişmelerin, hayatımıza birçok farklı yolla dokunacağına eminim, siz ne dersiniz?






Yorum yazabilmek için oturum açmalısınız.